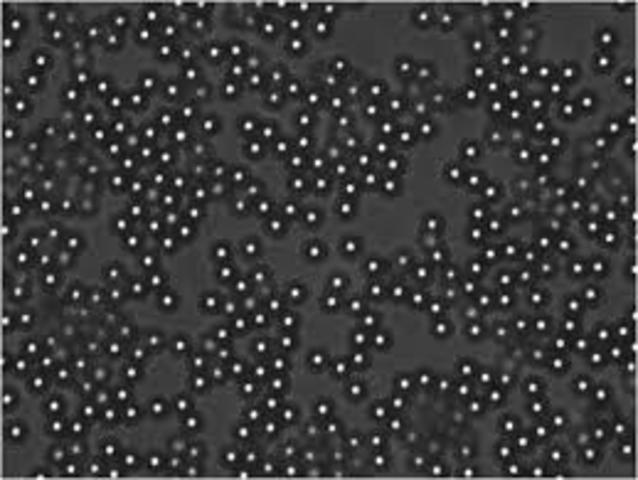
Difraccion de la luz

-
Coloides han sido estudiadas por los científicos desde principios de 1800.
-
Selmi, preparo dispersiones de Azufre, Azul de Prusia y Caseína. A partir de diversos experimentos concluyó que estos no se comportaban como soluciones verdaderas, sino como ¨suspensiones¨ de pequeñas partículas en agua.
-
Thomas Graham estudio la difusión de las sustancias disueltas distinguió dos clases de solutos a los que denomino cristaloides y coloides.
-
John Tyndall explicó cómo las partículas coloidales en una disolución o en un gas son visibles porque reflejan o refractan la luz. A simple vista, estas partículas no son visibles.
-
Freindlich investigó los fenómenos de adsorción que involucraba a los coloides.
-
Importantes descubrimientos sobre el tamaño y movimiento de las partículas coloidales fueron realizados por Smoluchowsky (1906), Svedberg (1906), Perrin (1908) y Einstein (1908).
Plan projects on a visual timeline
Map milestones, phases, deadlines, and key events in one place so the sequence is easier to see and share. Timetoast is a timeline maker for work, school, research, and stories.